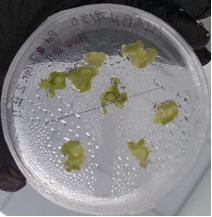

Plant Tissue Culturing Draws to a Close
January 24, 2025 2025-11-16 0:30Plant Tissue Culturing Draws to a Close
By Pratyusha Soni


Over the course of a few months, students in Applications of Biotechnology micro-propagated wild tobacco plants. Students started by sprinkling plant seeds from last years’ plant clones (preventing contamination by sterilizing the seeds!) onto media plates. When the plated seeds transformed into plantlets, the leaves were dissected and placed onto a plate containing hormones to facilitate the transition into a callus, undifferentiated plant cells that would then specialize into roots and shoots.

Pictured above: the development of a callus in the plant tissue culture process.
Over the course of a few weeks, the callus began to differentiate – the leaves grew first, and once the leaves began to mature, the plant was transferred to a new media which contained hormones to promote the growth of the SAM, or specialized shoots/root cells. Once the roots began to touch the bottom of the cups, it was time to transplant into a closed tissue culture chamber. Initially, the chamber was sealed, but gradually the covering on the ventilation holes was removed to slowly acclimate the plants to external environmental factors such as humidity and to ensure that the plants would survive in a non-sterile environment once they would be placed into individual pots. On the last day of the fall semester, the mature plants were potted, and they continue to grow: the seeds from these plants will be used again next fall as an incoming class prepares to clone plants!

The picture above, taken during the first week of the spring semester, highlights the plants’ growths and emphasizes the importance of maintaining a precise sterile environment throughout the micro-propagation journey,